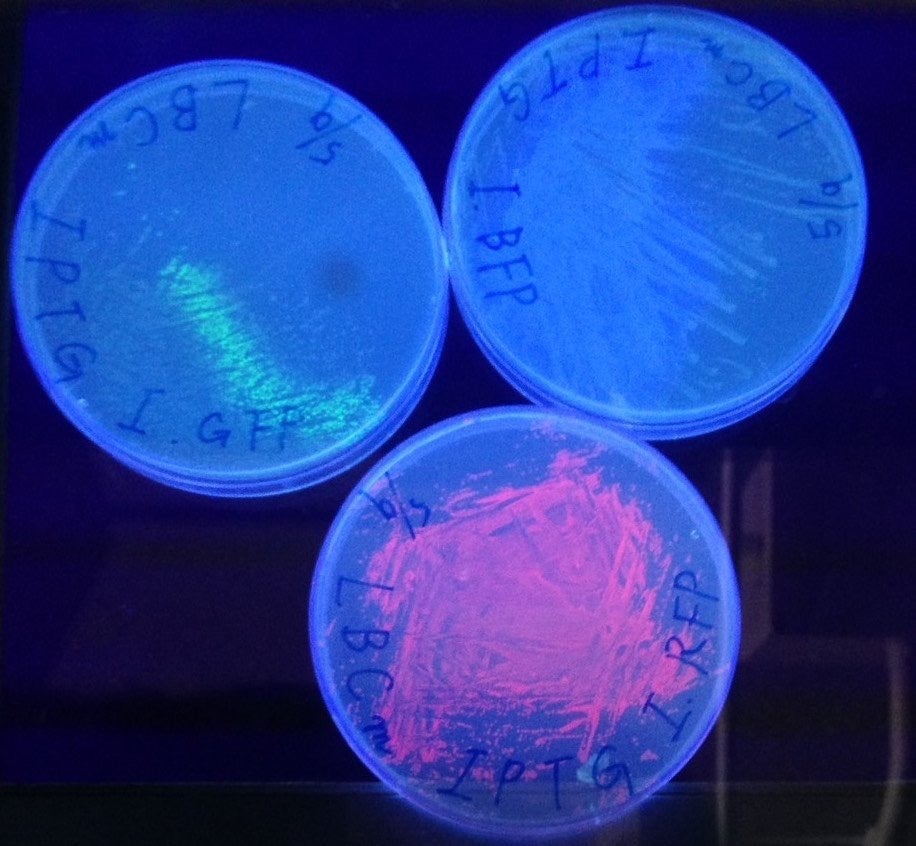

合成生物学の国際大会に挑戦
毎年11月ごろにマサチューセッツ工科大学で開かれるiGEMという大会は合成生物学において世界最大規模です。大学生や大学院生のチームが世界中から参加しており、日本では岐阜大学の他に、東京工業大学や京都大学にもチームがあります。我々、岐阜大学チームは合成生物学や分子機能の分野に興味があり、研究に携わりたい人が集まってチームを組んでいます。今年の研究テーマは「無細胞系でタンパク質の大量合成を可能にする」です。
iGEMに挑戦する意味とこれまでの実績
我々はiGEMという活動を通じて合成生物学に出会いました。研究ができるという興味本位から合成生物学という分野を知り、ほかの分野への応用や与える影響から合成生物学に魅力を感じるようになりました。
2014年にiGEMに初参加して以来、iGEM Gifuは「世界で一番長いタンパク質が作りたい」ということをテーマに活動してきました。今年までに幣サークルでは銀賞3回、銅賞2回を獲得しています。
2018年のiGEMの大会で発表している様子。ボストンで開催されており、海外の学生と交流することができる場でもあります。
無細胞系でタンパク質を大量合成する
本年、iGEM Gifuは「環状RNA」をもちいてタンパク質を合成することに挑戦しています。タンパク質はDNAを転写したRNAを翻訳する「分子生物学のセントラルドグマ」という過程を経てタンパク質が合成されています。RNAは通常線状構造をしており、分子内に端 (始まり、終わり) が存在しています。これにより、通常RNA情報の翻訳が行われるとき「リボソーム」というタンパク質合成マシンは一回の反応で一つのタンパク質しか翻訳することができません。そこで、このRNAを環状にすることで、先の問題となっいていた端を除去でき、翻訳を一度の反応で半永久的に行うことが可能になります。
これについては1998年にPerrimanとAresが蛍光タンパクであるGFPの重合体、ポリGFP (普通よりはるかに長いタンパク質) を環状RNAで発現可能であるということを報告しています。しかしながら、このときに作製されたポリGFPは蛍光 (機能性) を示すことはありませんでした。これはタンパク質が合成されすぎたため、分子量の巨大化に伴い分子間力が大きくなり、タンパク質が分子内で凝集されてしまったと考えています。タンパク質は複雑な立体構造を維持することで活性を示すため、凝集してしまうと本来のはたらきを失ってしまいます。環状RNAを用いたタンパク質合成は自然界には未だ確認されていない翻訳系であり、自然界に存在する翻訳系と比較して格段にタンパク質合成能力が高いと考えられます。
そこでiGEM Gifuでは合成タンパク質の凝集を避ける方法を考案しました。それは長いタンパク質を合成するのではなく単量体 (普通の一つ分のタンパク質) を発現させることを考えました。自然界には1本のmRNAから数種類のタンパク質が合成されるという機構があります。つまり、環状RNA上でリボソームを高速回転させ、何度も翻訳を繰り返させることができるという可能性があるということです。本法は世界でも初の試みであり、産業に対してどの程度の影響があるかは未知数です。
大量タンパク質の合成はなにをもたらすのか
このタンパク質合成法が確立すれば医学や薬学に応用ができると我々は考えています。酵素をはじめタンパク質はヒトの生命活動を正常に維持していくうえで必要不可欠な物質です。糖尿病など疾病の治療に利用されている酵素も数多く存在し、それらは効率的に合成することが求められます。当チームのモノマータンパク質の大量合成法は酵素の効率的かつ迅速な合成に応用できる可能性があります。そのため、今後この大量合成を確立して医療応用を視野に入れた合成可能なタンパク質の特定を進めていく必要が急務であります。また、本法は無細胞系と呼ばれる非生物システムにおいても用いることができます。通常、無細胞系は大腸菌のような生物システムを用いてタンパク質を合成する場合に比べて、合成能力が劣ります。しかし、無細胞系の一部のシステムはタンパク質を「薬」として用いる場合に必要不可欠なプロセスである「精製」が楽で、産業応用した場合に大きな影響をもたらすことが想像されています。iGEM Gifuの環状RNAを用いたタンパク質の大量合成法は無細胞系の欠陥を補填する技術であり、将来的にはタンパク質・ペプチド系薬品の値段を下げる、通常では合成できない人工タンパク質の合成を「迅速に」可能にするというようなインパクトをもたらすことが予想されます。
資金提供のお願い
このiGEMという活動は魅力を感じる反面、多くの費用がかかります。まずiGEMという活動に参加するにあたり、約50万円が必要であり、それに実験で使う試薬があります。また、発表の場がボストンなので渡航費や宿泊費もかかります。提供していただいた資金の内訳はリターンとともに報告します。
多くのお金と時間がかかるiGEMですが、我々はそれをやるだけの意味を見出しています。このクラウドファンディングを通じてiGEM Gifuがなにを目指しているのかを知っていただきたいのと同時に、我々の活動に興味を抱いてくれた方にご支援をいただき、ともにチャレンジしていきたいと考えております!
資金の使い道
ご支援していただいたお金は主にボストンへの渡航費と宿泊費に使わせていただき、一部を無細胞系の試薬購入費に充てる予定です。
| 渡航費・宿泊費(5名分) | 400,000 |
| 試薬購入費 | 50,000 |
今後のスケジュール
2019年 5月 |
研究に関する情報収集、新入生の教育 |
6月 |
研究に関する情報収集、予備実験、論文の再現実験、テーマ研究 |
7月 |
テーマ研究、高等学校への出前講義 |
8月 |
他チームとの共同研究、インターラボ、テーマ研究 |
9月 |
研究資料のまとめ、発表原稿・プレゼンテーション作成 |
10月 |
世界大会(iGEM Giant Jamboree)への参加 |
11月,12月 |
学長、学部長、課程長への結果報告、今年度の反省、リターンの実施 |
もっと知りたいという方へ
iGEM、iGEM Gifuでの活動をもっと知りたいという方はiGEMホームページ、当チームのホームページを訪れてみてください。また、Twitterでは日々の活動や研究について情報発信しています。ぜひ見てみてください!
・iGEM ホームページ
・iGEM Gifu ホームページ
・iGEM Gifu Twitter
https://twitter.com/iGEMgifu
最新の活動報告
もっと見る
ポスターを掲示しました!
2019/06/13 19:51本日、学内の二箇所にクラウドファンディングの広告を掲示しました!学内でも私たちの研究について知っている人はまだひと握りだと思います。まずは多くの人に私たちの研究を知ってもらい、共感した方や興味を持ってもらった方にご支援をしていただけたらと思います!! もっと見る

コメント
もっと見る